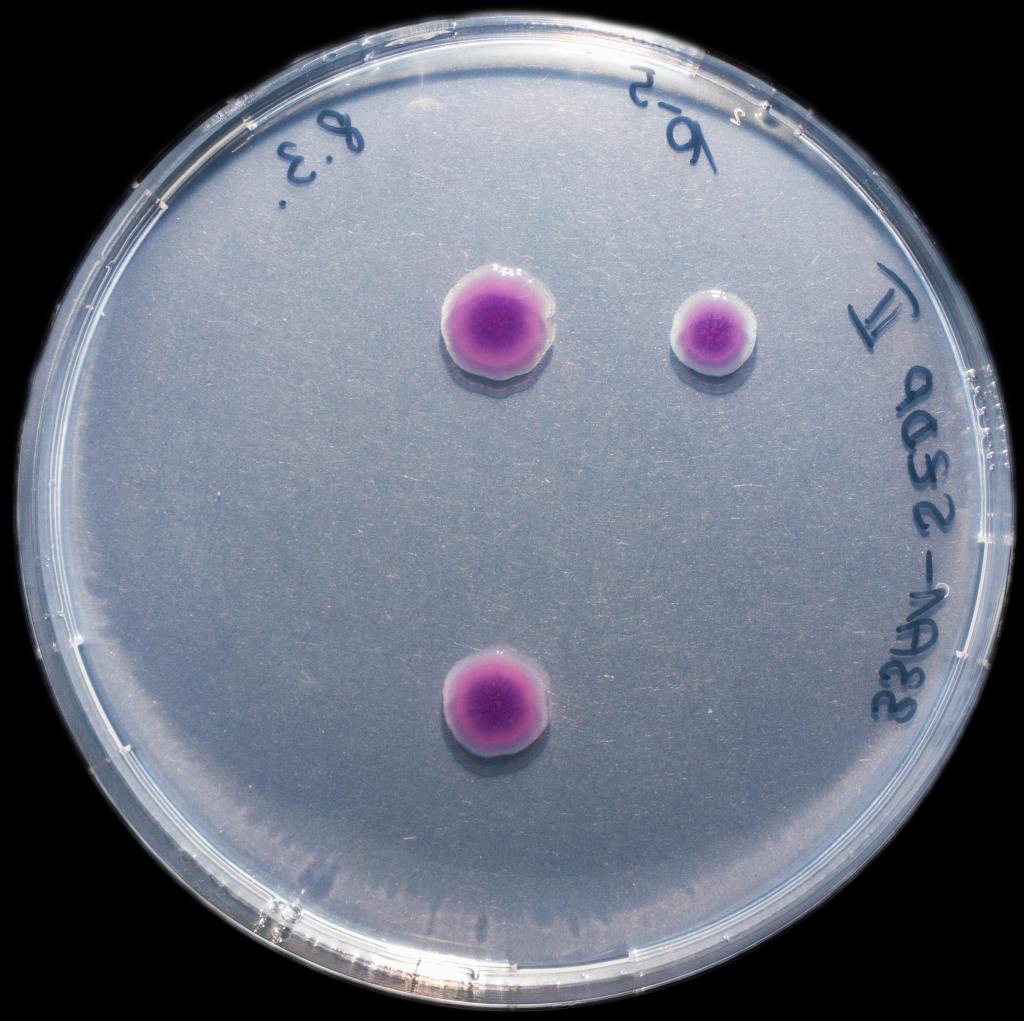
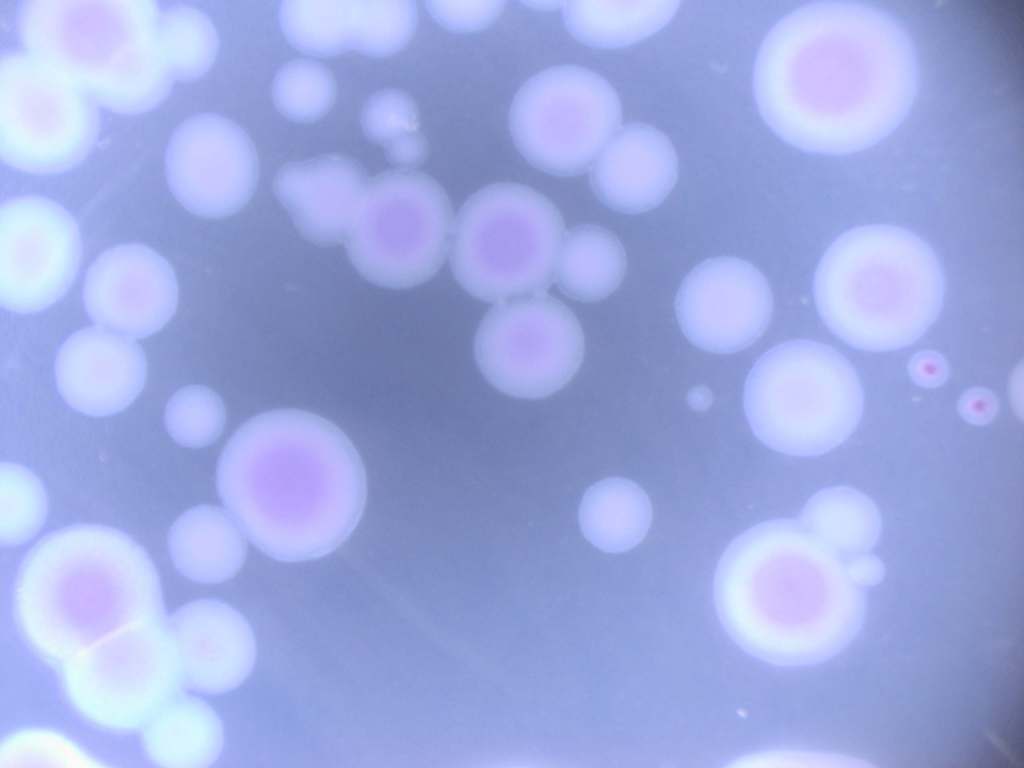
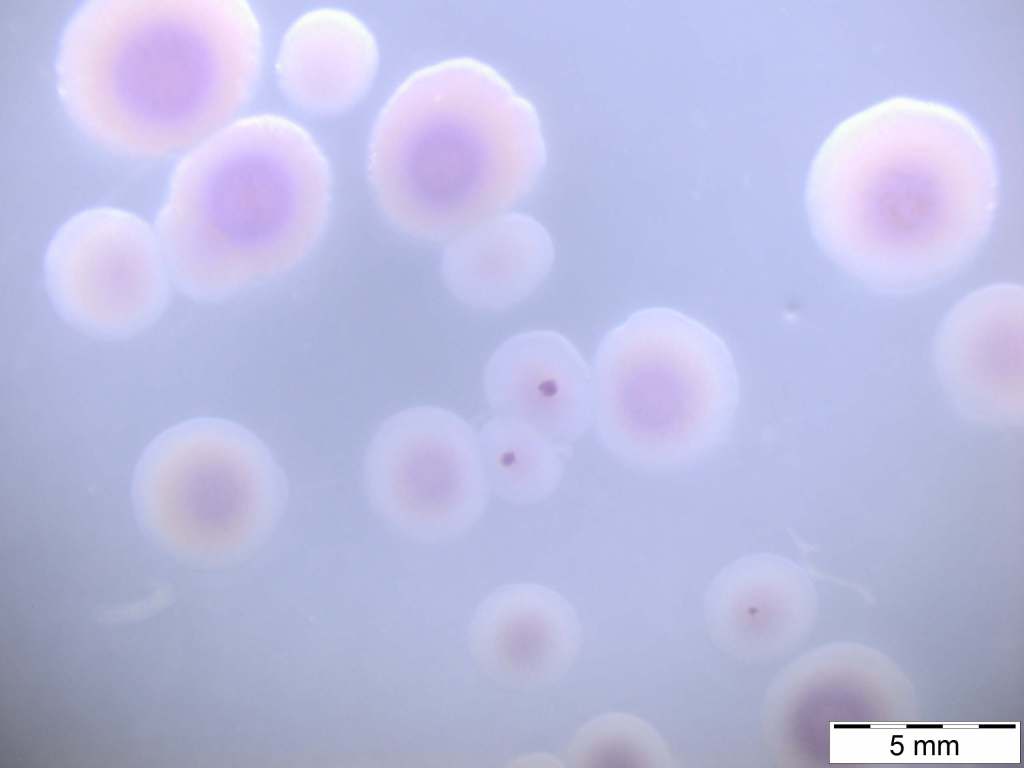

Anhand der Sequenzen des 16S rRNA Gens haben sich 4 interessante Gruppen herausgestellt, von denen nun Stämme weiter kultiviert werden:
Candidatus Rhodoluna limnophila
Diese Bakterienart ist als sogenannter Candidatus beschrieben. Das heißt, diese Art ist für die Beschreibung vorgesehen, aber es gibt noch keine wissenschaftliche Artbeschreibung. Im Fall von Candidatus Rhodoluna limnophila ist es schwierig Reinkuturen zu bekommen, da der Stamm meist mit anderen Bakterien vergesellschaftet wächst. Vielleicht haben wir Glück und bekommen eine Reinkultur. In diesen Gewässern kommt der ‚Kandidat‘ vor: 36-Hellb (Hellbrunner Bach)
Polynnucleobacter
Aus der Gattung Polynucleobacter von denen wir in der Arbeitsgruppe schon viele, viele Stämme isoliert und auch einige Arten beschrieben haben, sind auch einige dabei. Vielleicht finden wir hier eine neue Art. Von hier haben wir Stämme: 28-Watelile (Waldteich bei Linz), 30-AntBac (Antheringer Bach), 31-Felb (Felberbach), 35-AIB (Aigner Bach)
30S-AntBac
Dieser Stamm aus dem Antheringer Bach ist mit seinen nächsten verwandten Arten (z.B. Arcicella aquatica) nur zu ca. 93 % identisch. Dies würde bedeuten, dass es sich nicht nur um eine neue Art sondern auch um eine neue Gattung handelt.
33A1-SZDP
Den interessantesten Stamm hat Tamina aus einer Probe aus dem Salzachzufluss bei Puch kultiviert. Die am nächsten verwandte Art heißt Silvanigrella aquatica und wurde vom Projektteam aus einem kleinen Teich im Südschwarzwald isoliert. Aber auch mit diesem Stamm ist 33-A1 nur zu ca. 90 % identisch, es handelt sich also sicher um eine neue Gattung und eine neue Art. Auch im Labor ist der Stamm sehr interessant. In flüssigem Medium wächst er mal rötlich, mal grau-violett und mal ganz unspektakulär beige.





Auf Agarplatten macht er sehr schöne violette Kolonien:

Unter dem Mikroskop hat sich die Vermutung bestätigt, dass der Stamm in unterschiedlichen Formen wächst. Dazu wurden die Zellen mit einem fluoreszierendem Farbstoff angefärbt. Unter dem Mikroskop wird dieser Farbstoff dann mit UV-Licht angeregt und die Zellen leuchten blau. In einer neu angelegten Kultur wächst der Stamm in langen Filamenten, die gebogen sind. Dies sieht aus, wie eine Nudelsuppe in blau 😉 . In älteren Kulturen zerfallen diese Filamente dann in einzelne Zellen.

